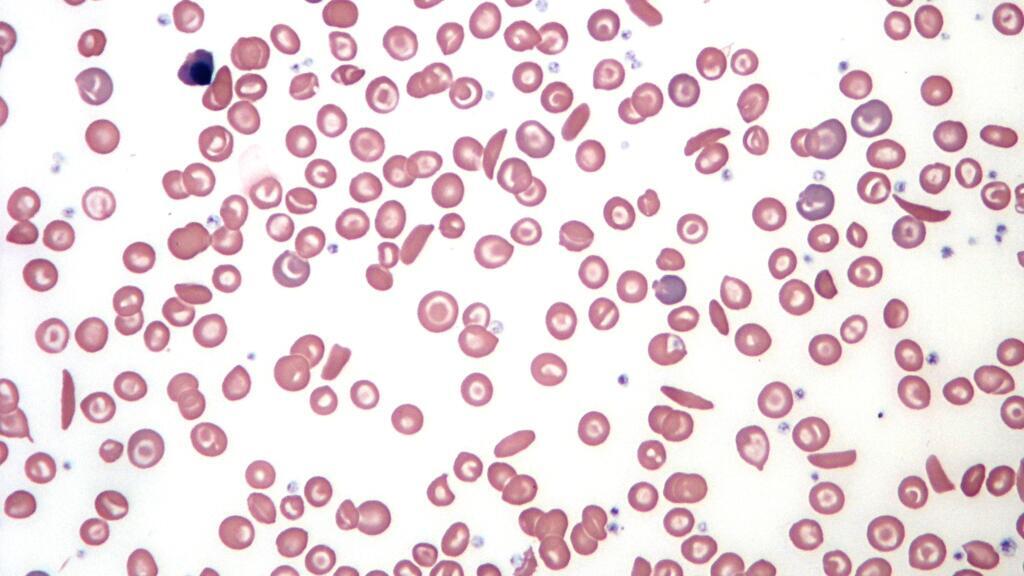

Lekki Drépanocytose hesi heɓike. Kiin ko Drepaf. Ko Sénégal ki moƴƴina. Ko ngol Laawol ɗoo woni go’o yo lekki ndee nawnaare ƴiiƴam moƴƴine Senegal. E bi’ol manufacture Teranga Pharma, fewnuɗo kin on, kii lekki haɗay nawnaare nden loorugol ka ɓanndu, dartina muuseendi.
Primeur link

